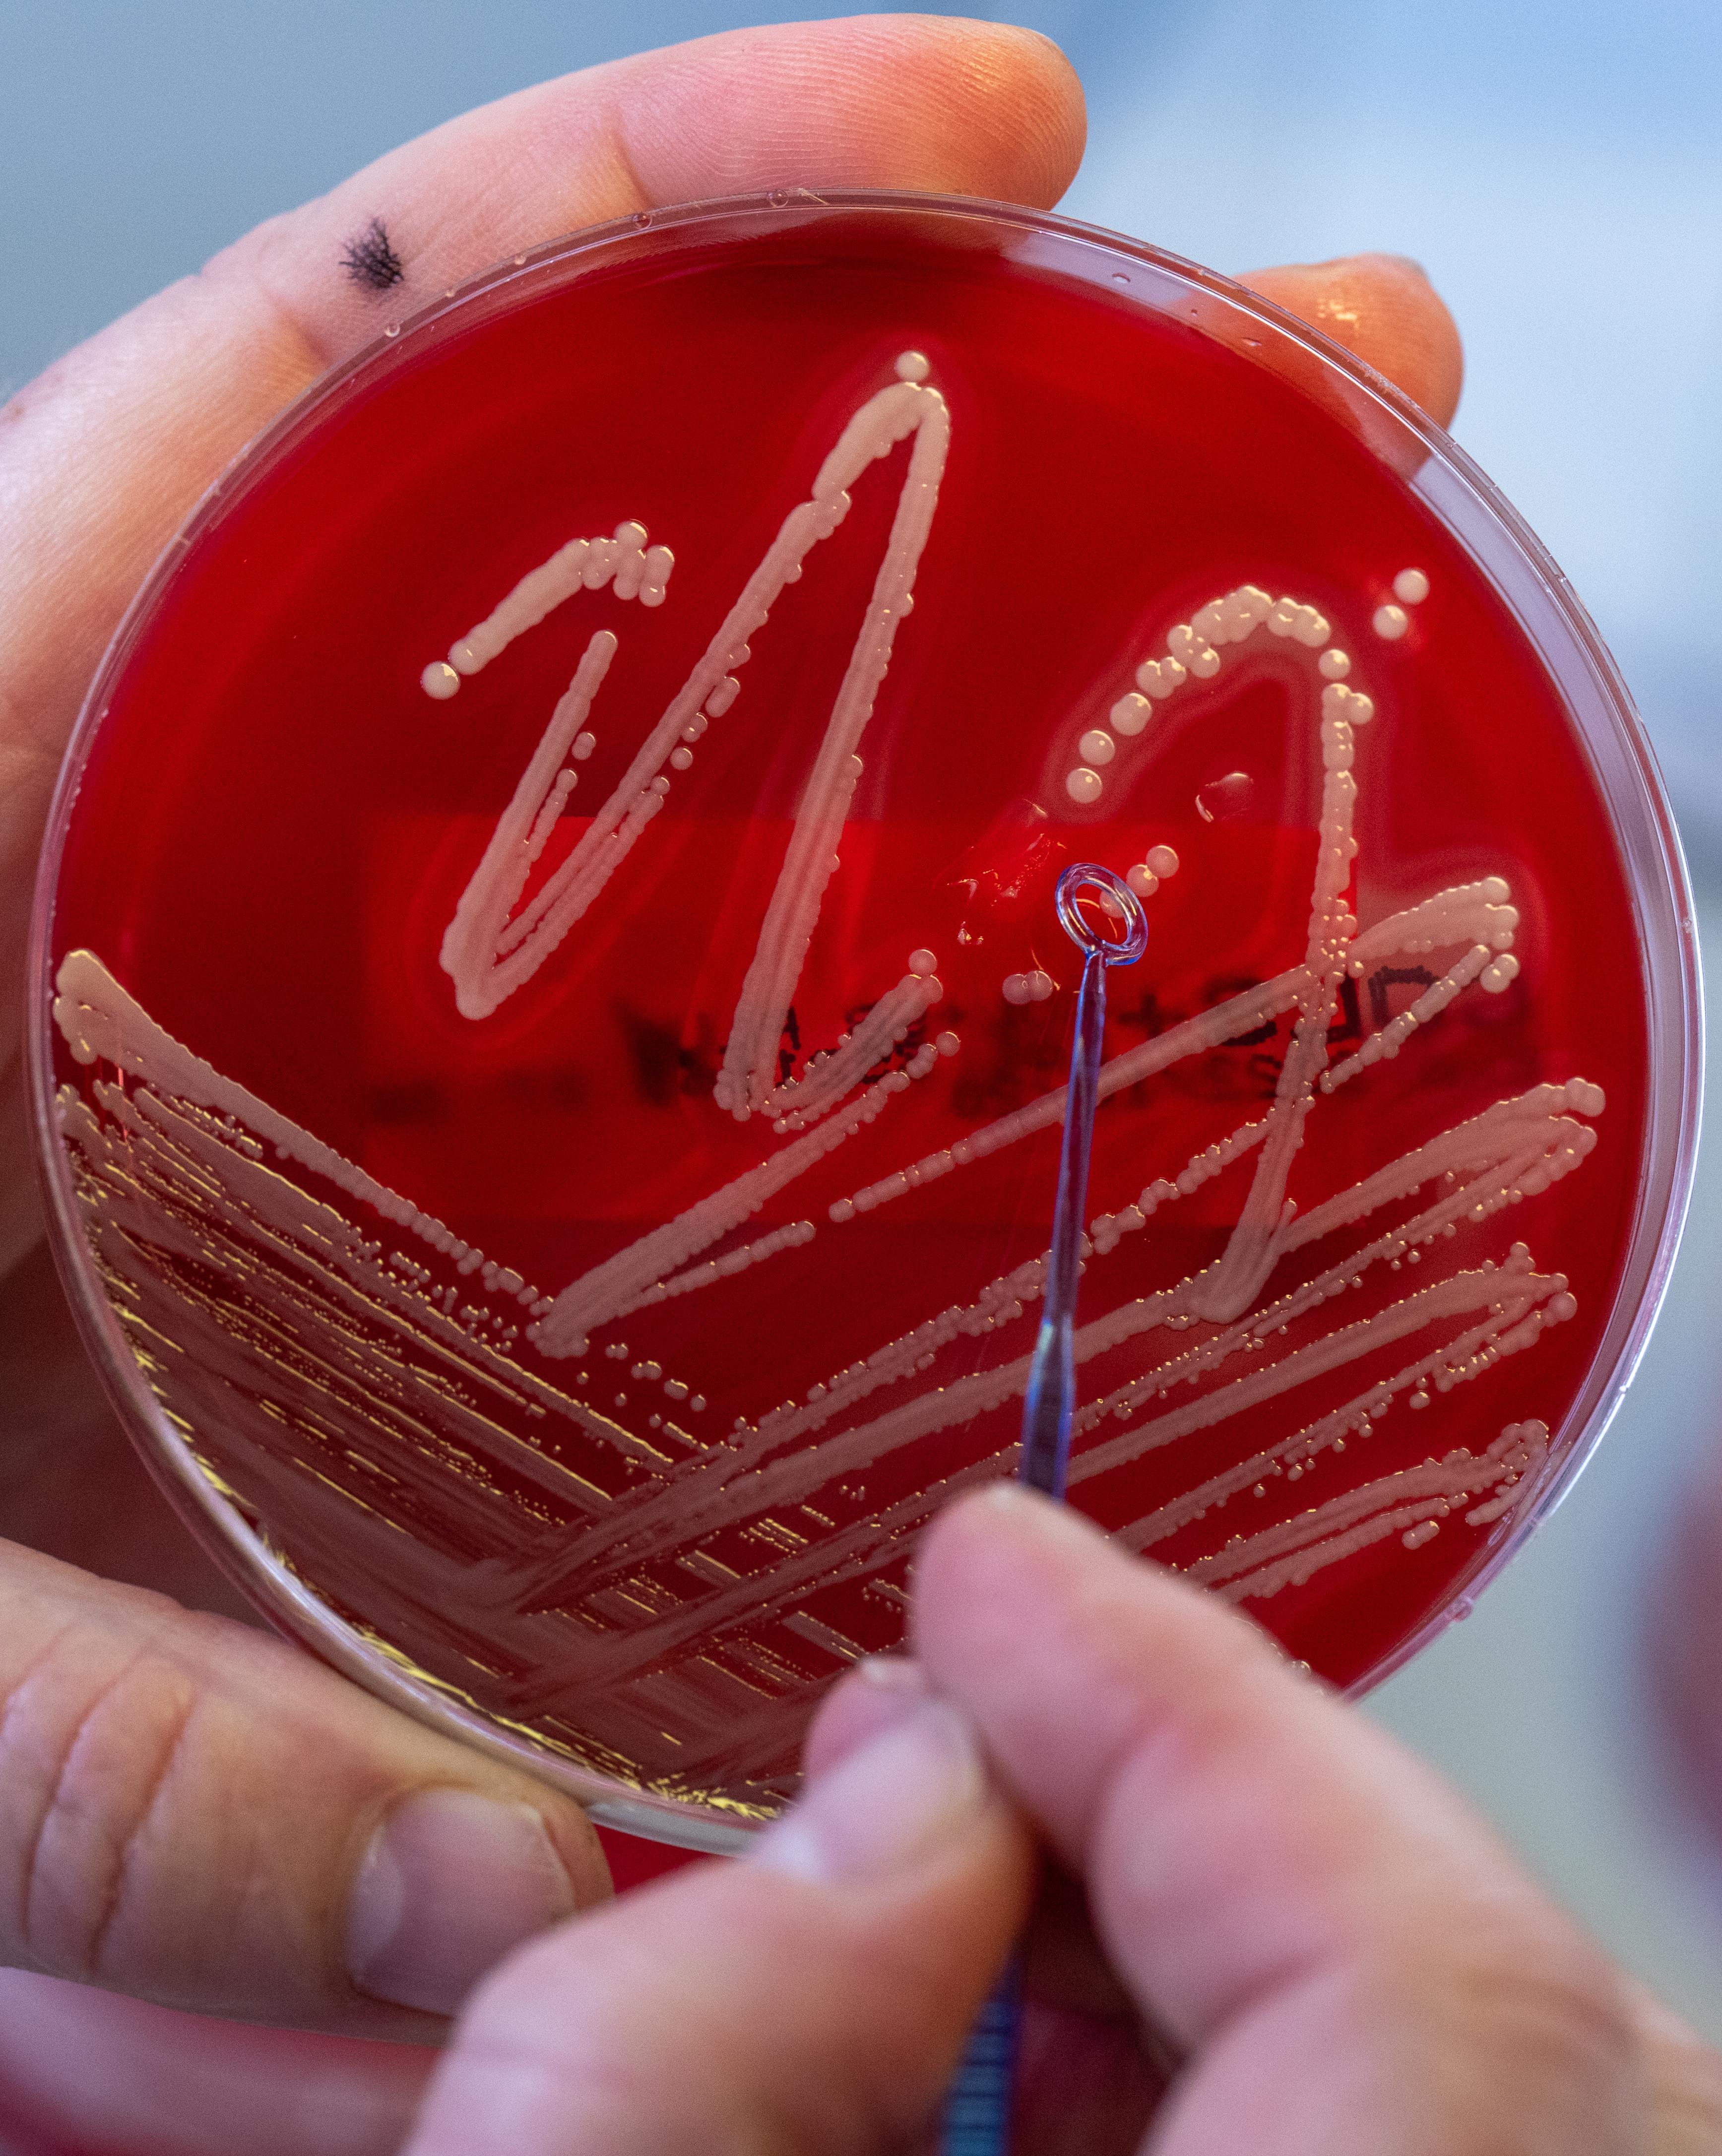
Kulturen des Bakteriums Staphylococcus aureus
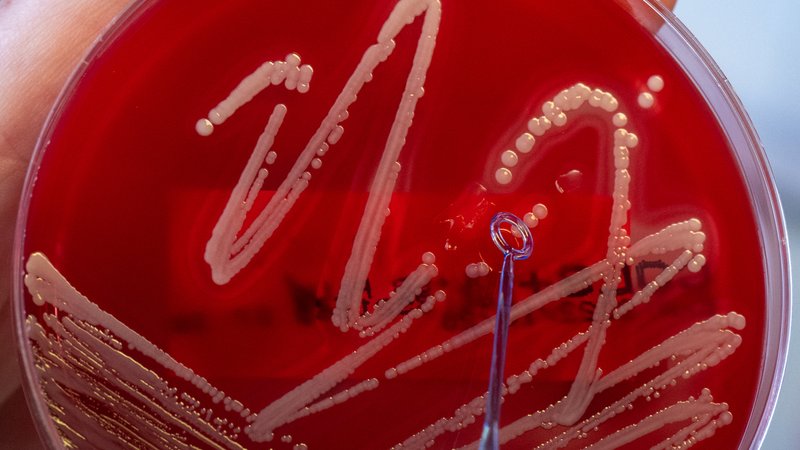
Kulturen des Bakteriums Staphylococcus aureus | Bild: picture alliance/ dpa/ Hendrik Schmidt Kulturen des Bakteriums Staphylococcus aureus

Bakterien müssen, um überleben zu können, Proteine herstellen. Ihre Proteinfabriken sind die sogenannten Ribosome, die in ihrer Zellflüssigkeit schwimmen. In einem Bereich der Ribosome werden einzelne Aminosäuren zu einer langen Kette aneinandergefügt, bis ein Protein fertig ist. Klassische Antibiotika blockieren diesen Produktionsbereich, sodass keine Proteine gebaut werden können. Ohne Proteine geht ein Bakterium aber zugrunde, etwa weil es seinen Stoffwechsel nicht aufrecht erhalten kann.
- Zum Artikel: Antibiotikaresistenzen: Die Angst vor Superkeimen
Cresomycin verhindert Resistenzen
Damit das klappt, müssen sich Antibiotika-Moleküle möglichst nahtlos und auch beständig an eine Bindungsmulde der Ribosome anheften. Weil sie weich und flexibel sind, passen sie gut hinein, können aber leicht wieder herausrutschen. Wenn sich zum Beispiel durch natürliche Mutationen diese Bindungsmulde verändert, funktioniert das Andocken nicht mehr. Die Antibiotika-Moleküle können sich nicht halten oder rutschen heraus. Dann ist das Bakterium resistent gegen den Wirkstoff. Er wirkt dann nicht mehr, die Bakterien können Proteine herstellen und sie können sich ungehindert vermehren. Bei Cresomycin ist das anders. Der antibiotische Wirkstoff verhindert diese Art der Antibiotika-Resistenz.
Cresomycin - synthetisches Antibiotikum aus dem Labor
Normalerweise werden Antibiotika-Wirkstoffe biotechnologisch von Mikroorganismen, also durch natürliche Produzenten hergestellt. Nicht aber Cresomycin. Ein Team um Yuri Polikanov von der Universität Chicago nahm sich die resistenten Ribosome vor. Mit der Röntgenkristallographie bildeten sie ihre Struktur exakt ab. Diese Abbildung war die Vorlage für Andrew Myers von der Harvard University. Sein Ziel: ein antibiotisches Molekül zu bauen, das exakt zu der visualisierten Struktur der Ribosome passt. Dadurch sollte sich der antibiotische Wirkstoff perfekt in die Bindungslücke der Ribosome einfügen. Und die hatte das Team durch die Vorlage aus der Röntgenkristallographie.
"Aber nach dem heutigen Stand der Technik kann man kein Bakterium dazu bringen, ein so exaktes, antibiotisches Molekül, das Andrew Myers kreieren wollte, perfekt zu produzieren", sagt Prof. Mark Brönstrup vom Helmholtz Zentrum für Infektionsforschung. Stattdessen hat das Harvard-Team ein synthetisches Molekül aus chemischen Bausteinen im Labor gebaut. Das passt jetzt perfekt in die Bindungsmulde.
Chemischer Synthese-Trick: Versteifung
Das synthetische Antibiotikum kann aber noch mehr: Es kann nicht aus der Bindungslücke der Ribosome herausrutschen, wie das bisherigen Antibiotika passieren kann. Um das zu erreichen, griffen die Wissenschaftler zu einem Trick: Sie versteiften das synthetische Molekül. Wenn es jetzt nahtlos an der Ribosom-Bindungsmulde eines Bakteriums andockt, ist die Bindung zwischen dem antibiotischen Molekül, also dem Wirkstoff, und dem Bakterium viel zu fest für ein Herausrutschen.
Durch die Versteifung sind auch natürliche Mutationen, also Veränderungen der Bindungsmulde nicht mehr möglich. Dazu sitzt Cresomycin zu fest. "Das ist zwar keine Revolution in der Antibiotika-Forschung, denn das Prinzip, die Proteinproduktion zu stören, ist nicht neu. Aber es ist auf jeden Fall eine gut gemachte Studie und eine sehr gute Arbeit", sagt Mark Brönstrup.
Cresomycin tötet Bakterien in vitro und in vivo
Und es funktioniert: Cresomycin hemmt in Zellkulturen und bei Mäusen multiresistente Stämme von Staphylococcus aureus, Escherichia coli und Pseudomonas aeruginosa. Mark Brönstrup: "Jetzt muss nachgewiesen werden, dass der Wirkstoff verträglich und sicher ist. Erst dann kann man ihn am Menschen testen."
Was ist eine Antibiotikaresistenz?
Viele Infektionen werden durch Bakterien verursacht. Um die Krankheitserreger zu stoppen, muss man sie vollständig abtöten oder ihre Vermehrung hemmen. Das ist die Aufgabe von Antibiotika. Diese Medikamente enthalten Wirkstoffe, die gesundheitsschädliche Bakterien vernichten können. Das hat seit der Einführung von Penicillin, das 1941 als erstes Antibiotikum auf den Markt kam, sehr gut funktioniert.
Bakterien können sich aber gegen Angreifer schützen. Das passiert einerseits per Zufall. Denn Bakterien vermehren sich bei einer Infektion, die sie hervorrufen, millionenfach. Dabei kann sich durch eine natürliche Mutation das Erbgut eines Krankheitserregers so verändern, dass er unempfindlich gegenüber einem Wirkstoff eines Antibiotikums wird. Das Bakterium hat dann eine Resistenz, also einen Widerstand gegen ein Antibiotikum entwickelt. Es überlebt, kann sich vermehren und gibt dabei die Widerstandsfähigkeit über die Gene an seine Nachkommen weiter.
Bakterien können aber auch Resistenzen an andere Erreger übertragen, denn sie sind in der Lage, Gene untereinander auszutauschen. Sammelt ein Bakterium viele verschiedene Resistenzen ein, dann können ihm mehrere Wirkstoffe von verschiedenen Antibiotika nichts mehr anhaben. Das Bakterium ist dann multiresistent: ein multiresistenter Keim.
MRSA, der sogenannte Krankenhauskeim, ist so ein multiresistenter Keim. Er kommt in verschiedenen Varianten vor und ist unempfindlich gegen viele gängige Antibiotika. Multiresistente Keime können Menschen gefährlich werden, deren Immunsystem geschwächt ist. Deshalb besteht in Krankenhäusern, Arztpraxen und Pflegeeinrichtungen ein erhöhtes Risiko, sich mit ihnen zu infizieren, weil viele Menschen auf engem Raum beieinander sind. Circa 400.000 bis 600.000 Menschen erkranken in Deutschland an Infektionen, die durch multiresistente Keime verursacht werden. Circa 15.000 Patienten sterben durch sie.
Haben Bakterien noch andere Möglichkeiten, immun gegen Antibiotika zu werden?
Bakterien sind erfinderisch, denn sie wollen ja überleben. Sie können zum Beispiel eigene Waffen produzieren: Proteine, also Eiweiße, die Antibiotika inaktiv machen. Sie können auch ihre Zellmembran so verändern, dass sie weniger durchlässig ist. Dadurch kann nur noch eine geringere Menge des antibiotischen Wirkstoffs die Bakterien attackieren. Und sie können sogar Proteine bilden, die das Antibiotikum aus ihrem Körper herauswerfen.
Alternativen: Bakterienfresser können Antibiotika teilweise ersetzen
Bakterien haben einen gefräßigen Feind: Viren. Sogenannte Bakteriophagen, oder kurz: Phagen. Ihr Vorteil: Für den Menschen sind sie ungefährlich. Aber nicht für Bakterien. Die Viren benutzen sie als Wirtszellen für ihre eigenen Nachkommen.
Phagen heften sich an Bakterien an und schleusen ihre Erbinformation in sie hinein. Dabei werden die Bakterien so umprogrammiert, dass sie keine eigenen Nachkommen mehr produzieren können. Stattdessen produzieren sie in ihrem Körper lauter neue Phagen – ihre eigenen Feinde. Das geht solange, bis die Bakterien platzen und die Viren freigeben. Die neue Virengeneration greift die nächsten Bakterien an.
Bakteriophagen können zum Beispiel Diabetikern helfen, die offene, entzündete Wunden haben. Aber sie kommen nicht immer gegen antibiotikaresistente Staphylococcus aureus-Stämme (MRSA) an, also multiresistenten Keime.
Intelligente Gegenwehr: Trojanische Pferde gegen Bakterien
Auch das Team von Mark Brönstrup vom Helmholtz Zentrum für Infektionsforschung stellt synthetische Substanzen her, die antibiotisch wirken. Die sollen zusätzlich mit einem Lockmittel zusammengepackt werden, dem Bakterien nicht widerstehen können: Eisen. Bakterien brauchen Eisen, das ist ein wichtiger Nährstoff für sie. Bakterien reagieren auf den Lockstoff und ziehen ihn in sich hinein: Und damit auch den Wirkstoff, in dem sie verpackt sind. Der kann sie angreifen und abtöten.
Was leistet in Zukunft die KI? Fahnden nach neuen Wirkstoffen aus Naturstoffen
Forscher haben in den letzten Jahren tausende neue Naturstoffe gefunden und diese genetisch entschlüsselt. Könnten unter ihnen Kandidaten sein, die sich für neue antibakterielle Wirkstoffe eignen?
KI, also künstliche Intelligenz, unterstützt dabei, passende Antibiotika zu finden. Wissenschaftler füttern eine KI mit Daten über krankmachende Keime, unter anderem über ihre genetischen Eigenschaften und wie sie auf verschiedene Antibiotika reagieren. Die KI wird auch mit Daten der Eigenschaften der antibiotischen Medikamente gefüttert. Sie berechnet dann die Wahrscheinlichkeit, welche Abwehrmechanismen der Keime zu Resistenzen führen. Und die KI berechnet auch, welche Naturstoffe fähig sein könnten, diese Abwehrmechanismen zu umgehen oder sie zu durchbrechen. Letztendlich ist das ein Prozess, der einige Jahre dauert. Denn bis es zu neuen Antibiotika aus Naturstoffen kommt, müssen die Wirkstoffe biotechnologisch produziert und dann an Zellkulturen, Tieren und letztendlich am Menschen getestet werden.
- Zum Artikel: Bakteriophagen statt Antibiotika
Das ist die Europäische Perspektive bei BR24.
"Hier ist Bayern": Der BR24 Newsletter informiert Sie immer montags bis freitags zum Feierabend über das Wichtigste vom Tag auf einen Blick – kompakt und direkt in Ihrem privaten Postfach. Hier geht’s zur Anmeldung!